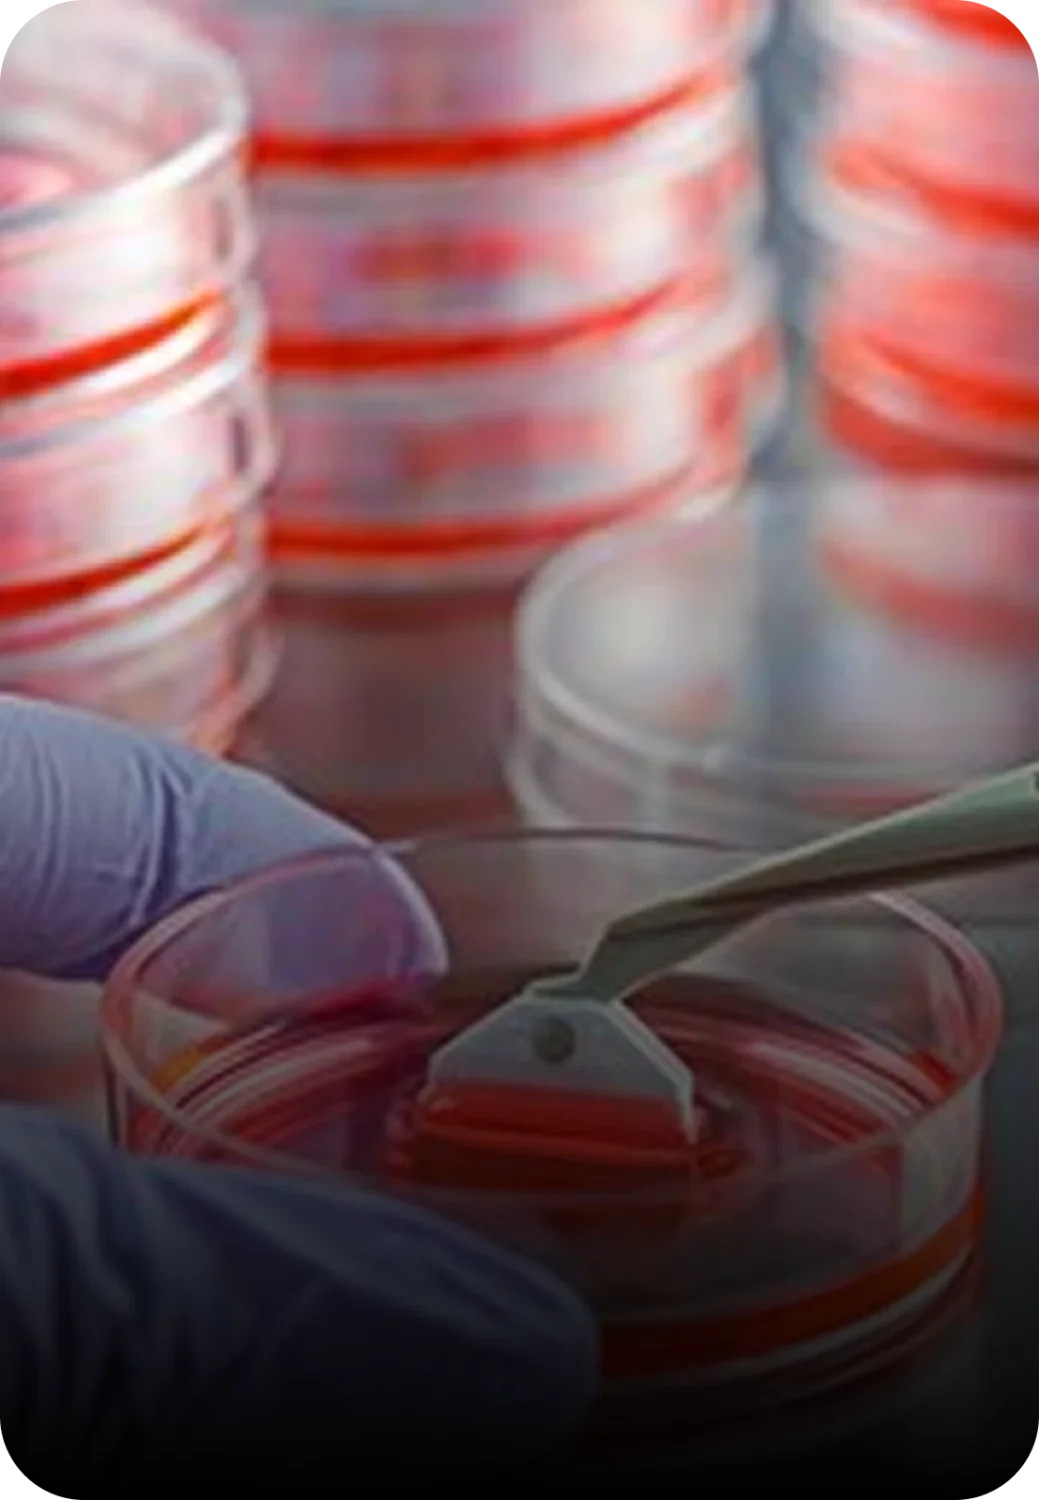

SCIENCE MOVES FASTER WHEN SUPPLY IS CERTAIN
• ELISA Kits • Enzymes • Nanoparticles
• VHH Discovery • Viral vectors














High-Demand Immunodetection Reagents

ELISA Detection Kits
Secondary antibodies and immunoglobulin detection reagents used in quantitative ELISA assays.
ELISA Kits >
Western Blot Detection Antibodies
Secondary antibodies designed for sensitive protein detection and signal amplification.
WB Antibodies >
Immunohistochemistry Reagents
Antibodies used in tissue-based immunodetection and pathology workflows.
IHC Antibodies >
Clinical Immunology Reagents
Light chain and immunoglobulin detection antibodies used in research and clinical immunology.
Antibodies For Diagnostics >Explore
Capabilities To Advance Your Programs
Specials & Promotions
Featured Products & Services

NEW! AbNano® VHH Anti-NK-Cell Library
AbNano® introduces a first-in-class peripheral NK cell-derived VHH library designed to help researchers identify differentiated binders for challenging NK-associated targets. Built for NK target discovery, CAR- NK research, and advanced screening workflows, with optional discovery services to accelerate progression from hit to lead.
Popular Resources
News & Events
See All Fortis News >

Fortis Life Sciences Names Deliver Biosciences The Winner
Of the Fortis Grant Series, featuring AbNano VHH Discovery Services

PEGS Boston. May 11-15, 2026
The Essential Protein and Antibody Engineering Summit

ADLM, Anaheim. July 28-30, 2026
The Association for Diagnostics & laboratory Medicine

Fortis Life Sciences Expands AbNano® Portfolio with
First Peripheral Natural Cell-Derived VHH Library
First peripheral natural killer cell-derived single-domain antibody VHH library.


PEGS Boston. May 11-15, 2026
Meet us at the Essential Protein and Antibody Engineering Summit Booth 620.


Fortis Life Sciences Names Deliver Biosciences The Winner
Of the Fortis Grant Series, featuring AbNano VHH Discovery Services


AbNano VHH Products and Services
For Targets that Demand Precision Choose VHH Domains


ADLM, Anaheim. July 28-30, 2026
See us in Booth 1521 at the Association for Diagnostics & Laboratory Medicine.


One Force Forward
Scientific progress depends on the reagents, technologies, and expertise behind every experiment. Fortis Life Sciences brings together specialized companies spanning antibodies, diagnostic components, molecular biology reagents, engineered nanoparticles, and viral vector platforms. Together they form One Fortis.
About UsWhere Science Finds Momentum
North American manufacturing and R&D locations,
with three ISO 13485 certified and GMP
compliant sites.
North American manufacturing and R&D locations, with three ISO 13485 certified and GMP compliant sites.
Biopharma, diagnostics,
research, and applied technology
customers globally
Biopharma, diagnostics, research, and applied technology customers globally
Academic and peer-reviewed
citations
Academic and peer-reviewed citations
Explore how stem cells self-renew and differentiate into specialized cell types, supporting tissue regeneration, development, and the maintenance of healthy biological systems.
Read more >
Learn how the immune system detects and eliminates cancer cells using antibodies, immune checkpoints, and engineered immunotherapies.
Read more >
See how cells recycle damaged proteins and organelles through autophagy, a critical process that maintains cellular balance and supports survival under stress conditions.
Read more >
Discover how nanoscale materials interact with biological systems to enable targeted drug delivery, advanced diagnostics, and innovative therapeutic technologies.
Read more >
Explore how tumor cells spread from a primary site to distant organs, the barriers circulating tumor cells face in establishing metastases, and why metastatic disease is associated with poor prognosis.
Read more >
Learn how the cell cycle phases (G1, S, G2, M), checkpoints, and regulators such as cyclins and cyclin-dependent kinases control cell proliferation and maintain genomic integrity.
Read more >
One Fortis.
Global Reach.
Fortis integrates specialized expertise across one Farm-to-Bench™ system to support the discoveries that define what comes next in science.
To find a representative or distributor in your area click on the region and scroll through the list.
North America